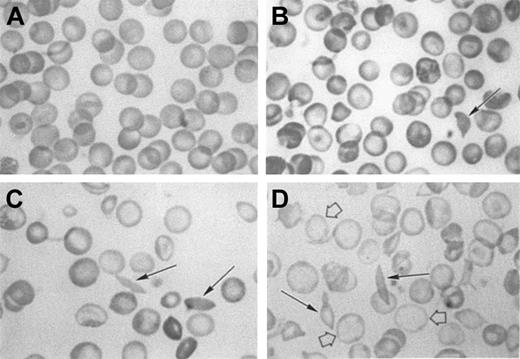
Fig. 2. Morphology of red cells from C57BL, NY1KO γH, NY1KO γM, and BERK mice. / (A), C57BL; (B), NY1KO γH; (C), NY1KO γM; and (D), BERK mice. Note that the NY1KO γH mouse red cells are hyperchromic when compared with C57BL, and the BERK mouse red cells are hypochromic (open arrows). Solid arrows indicate circulating irreversibly sickled cells (ISCs) that can be found in all 3 types of transgenic mice. The red cells of the NY1KO γH mouse are normochromic or hyperchromic when compared with the control C57BL mouse and, in contrast, the red cells of the BERK mouse are severely hypochromic when compared with the C57BL mouse. These results are in agreement with the Percoll-Larex continuous density gradients (Figure 1), which show that the BERK mice have a much lower MCHC than either NY1KO γM or γH mice. This is particularly apparent when the BERK mice are compared with the NY1KO γM mice that have approximately the same average reticulocyte counts.

Abstract
Sickle transgenic mice expressing exclusively human globins are desirable for studying pathophysiology and testing gene therapy strategies, but they must have significant pathology and show evidence of amelioration by antisickling hemoglobins. Mice were generated that expressed exclusively human sickle hemoglobin with 3 levels of HbF using their previously described sickle constructs (cointegrated human miniLCRα2 and miniLCRβS [PNAS 89:12150, 1992]), mouse α- and β-globin-knockouts, and 3 different human γ-transgenes. It was found that, at all 3 levels of HbF expression, these mice have balanced chain synthesis, nearly normal mean corpuscular hemoglobin, and, in some cases, F cells. Mice with the least adult HbF expression were the most severe. Progressive increase in HbF from less than 3% to 20% to 40% correlated with progressive increase in hematocrit (22% to 34% to 40%) and progressive decrease in reticulocyte count (from 60% to 30% to 13%). Urine concentrating ability was normalized at high HbF, and tissue damage detected by histopathology and organ weight were ameliorated by increased HbF. The γ-transgene that produces intermediate levels of HbF was introduced into knockout sickle mice described by Pàszty and coworkers that express the miniLCRα1GγAγδβStransgene and have fetal but not adult expression of HbF. It was found that the level of HbF required to ameliorate low hematocrit and normalize urine concentrating defect was different for the miniLCRα2βS and miniLCRα1GγAγδβS mice. We conclude that knockout mice with the miniLCRα2βS transgene and postnatal expression of HbF have sufficiently faithful sickle pathology to serve as a platform for testing antisickling interventions.
Introduction
Sickle cell disease is due to a single amino acid replacement that results in polymerization of deoxyhemoglobin and red cell sickling. Patients with the disease suffer from pleiotropic effects that impact nearly every organ in the body. Both the frequency and extent of vaso-occlusion are affected by a multitude of factors: both environmental and genetic (such as β-gene cluster haplotype, α-thalassemia, HbF expression, gender, and the effects of other epistatic genes). Because of the complexity of the disease, animal models are needed to dissect the mechanisms of pathology and to serve as a models for testing therapeutic strategies, including gene therapy.
Some of the earliest transgenic mouse models failed to produce full-blown pathology because of absence of human α, low expression of βS, and/or because mouse α-chains are as effective an inhibitor of polymerization as human γ-chains.1Introduction of human α-globin and deletion of the mouse βmajor2-5 increased intracellular polymer formation.6 Another advance was the introduction of dominant sickle globin genes: βS-Antilles7 or the recombinant construct βSAD.8-11 However, mouse globins and supersickling globins can greatly complicate the interpretation of the effect of antisickling globins proposed for use in gene therapy by: (1) requiring mouse α, which is an antisickling globin,1,12 for viability; (2) introducing a high or low oxygen affinity that alters the probability that βS will deoxygenate and form polymer at venous pO2; and (3) altering the nucleation process that can affect the delay time and affect probability of vaso-occlusion.8 Hence, mice expressing exclusively human α and βS are a desirable starting point for testing antisickling strategies.
Transgenic sickle knockout mice expressing exclusively human globins have been generated.13-15 These mice represent a significant advance toward the goal of producing improved models for sickle cell disease. However, the models reported to date (including the knockout mice described by Pàszty and coworkers13 that are homozygous for both mouse α- and β-globin knockouts and express the transgene miniLCR α1GγAγδβSHba0//Hba0 Hbb0//Hbb0, hereafter referred to as BERK, have both chain imbalance and very low mean corpuscular hemoglobin (MCH) and MCH concentration (MCHC), which make their utility as models for gene therapy problematic.
To create a model suitable for testing therapeutic and gene therapy strategies, we need to satisfy 2 aims: (1) produce a mouse model expressing exclusively human globins with balanced chain synthesis and normal MCH, and (2) create a series of benchmarks against which antisickling globins can be evaluated. The logical choice for the benchmark is postnatal expression of human fetal hemoglobin (α2γ2, HbF) at various levels. The models expressing exclusively human globins created to date either do not have significant postnatal expression of HbF,13-15 or express it in a number of different lines that are not strictly comparable.14
To reach these goals, we introduced the Pàszty et al α-knockout13 and the Yang et al β-knockout16 into mice that express our previously described sickle transgene generated by Costantini.4 This resulted in mice that can be described as miniLCRα2 miniLCRβS Hba0//Hba0Hbb0//Hbb,0 hereafter referred to as NY1KO. The mice were rescued from neonatal lethality by breeding in HbF with high expression during the fetal stage and different levels of postnatal expression, which we will name, in order of increasing postnatal HbF, NY1KO γL(ow), NY1KO γM(edium), and NY1KO γH(igh).
In this paper, we demonstrate the effect of 3 levels of postnatal HbF expression on the NY1KO model and the effect of 2 different levels on the BERK model. We conclude that the NY1KO model faithfully reproduces human sickle cell anemia.
Materials and methods
Transgenic mice
The generation of NY1 mice expressing cointegrated miniLCRα2 and miniLCRβS constructs was previously described by Costantini and coworkers4 and BERK mice expressing cointegrated miniLCR, α1, andGγAγδβS constructs by Pàszty and coworkers.13 Briefly, NY1 mice were generated by coinjecting 2 constructs: (1) an 8-kilobase (kb) miniLCR (locus control region) containing four 5′ hypersensitive sites (HS4: HumHBB 951-2199, HS3: 4279-5128, HS2:7764-9218, HS1: 10947-15180) ligated to the SacI-SacI fragment of the human α2 globin gene (HumHBA4:3896-8147) and (2) the same miniLCR ligated to the SphI-XbaI fragment containing the βS globin gene (HumHBB: 61571-65473), which then cointegrated. The BERK mice were generated by coinjecting 3 constructs: (1) a 6.4-kb miniLCR, (2) a 1.5-kbPstI fragment of the human α1 gene, and (3) a 39-kbKpnI fragment containing the humanGγAγδ and βS globin genes in their normal order, which then cointegrated.13
Two different γ-constructs were generated by Gilman et al17 (γM and γH) and a third construct γL (F1352) was generated by Forget and coworkers,18 line 1352. The γH (G100) construct17 19 consists of a fragment of HS4 (HumHBB 951-2204) that was amplified by polymerase chain reaction (PCR) from a volunteer with primer that includedBglII sites and was subcloned in pbluescript II upstream of a 12.4-kb BglII fragment (which runs from HumHBB32 837-45 203 and includes the 3′ enhancer) that contains both gamma globin genes. This BglII fragment originated from a sickle cell patient with the Senegal haplotype and therefore contains a T at position −158 relative to the cap site of the Gγ globin gene. The γM (G203) construct was identical to the γH construct, except that it included a PCR-generated 4.3-kb fragment (HumHBB 912-5200) containing HS 3 and 4 of the LCR instead of HS4. Injection of these constructs into fertilized mouse oocytes resulted in the production of several founder mice. One multicopy founder of each line was selected for further studies.
NY1 mice were bred onto a background of C57BL/6J mice and the mouse α- and β-globin knockouts that have been backcrossed onto C57BL from 7 to 11 times were bred in. The mouse α-globin knockout was obtained from Pàszty and coworkers.20 The mouse β-globin knockout used for the NY1KO mice was obtained from Smithies et al.16 The background of the BERK mice is more complex; they have been produced, at the Albert Einstein College of Medicine (AECOM), by breeding between BERK mice with full and partial knockouts for mouse β-globins and as such have a heterogenous background (including FVB/N, 129, DBA/2, C57BL/6, and Black Swiss). A limited amount of backcrossing onto C57BL has occurred at AECOM since the publication of the original description of these mice. In the BERK mice, the β-globin knockout was generated by Ryan and coworkers.14 The γL, γM, and γH mice used to produce the NY1KO mice, and the BERK γM mice were backcrossed onto the C57BL background from 4 to 7 times.
The breeding scheme to produce a NY1KO mouse from a founder requires one more step (to introduce the γ transgene) than that used for BERK mice13 and requires fewer steps than that used for the mice described by Chang et al.15 To breed mice on a day-to-day basis the following schemes are used: (1) The NY1KO γH mice breed successfully with each other. (2) For the NY1KO γL and γM mice, fully knocked out healthy females expressing neutral hemoglobins such as HbA (miniLCRαβAHba0//Hba0 Hbb0//Hbb0), HbC, AS, or AC, and a NY1KO γ male in which the γ is homozygous are used. This leads to a projected breeding efficiency similar to that for the BERK mice. A large number of other less efficient schemes also produce the desired mice as well as mice useable in other contexts.
All animals were maintained on “sickle chow” developed by Pàszty without added arginine and obtained from Purina (Purina Mills, St Louis, MO) as diet no. 5740C and had access to Nestlets (Ancare, Bellmore, NY) nesting material. For this paper, we studied 4 NY1KO γL,10 NY1KO γM, 20 NY1KO γH, 20 BERK mice, and 5 BERK γM mice.
Mouse nomenclature
Hemoglobin transgenes have a number of characteristics that will or may affect expression and potentially physiology: (1) the identity and number of hypersensitive sites in the LCR and its overall composition, (2) the number of copies, and (3) site of integration that can affect expression and cause variegation (expression in some cells and not in others).21 These features are not reflected in names that list the genes in the constructs. It is therefore important to give each transgenic line a unique and easy to remember nickname.
Following the tradition of hemoglobin nomenclature, we have assigned geographical place names for the transgenes used here (except for the γ transgenes) and generated 4 to 5 letter “nicknames.” Table1 lists a full description of each type of mouse.
Mouse nomenclature
| Nickname . | αβ Globin transgene name . | αβ Globin transgene description . | γ Globin transgene name* . | α KO . | β KO or deletion . |
|---|---|---|---|---|---|
| THAL | — | — | — | — | Hbbth-1//Hbbth-1† |
| NY1KO γL | NY1 | MiniLCRα2 miniLCRβS | γL | Hba0//Hba0‡ | Hbb0//Hbb01-153 |
| NY1KO γM | NY1 | MiniLCRα2 miniLCRβS | γM | Hba0//Hba0‡ | Hbb0//Hbb01-153 |
| NY1KO γH | NY1 | MiniLCRα2 miniLCRβS | γH | Hba0//Hba0‡ | Hbb0//Hbb01-153 |
| BERK | BERK | MiniLCR α1GγAγδβS | — | Hba0//Hba0‡ | Hbb0//Hbb01-155 |
| BERK γM | BERK | MiniLCR α1GγAγδβS | γM | Hba0//Hba0‡ | Hbb0//Hbb01-155 |
| Nickname . | αβ Globin transgene name . | αβ Globin transgene description . | γ Globin transgene name* . | α KO . | β KO or deletion . |
|---|---|---|---|---|---|
| THAL | — | — | — | — | Hbbth-1//Hbbth-1† |
| NY1KO γL | NY1 | MiniLCRα2 miniLCRβS | γL | Hba0//Hba0‡ | Hbb0//Hbb01-153 |
| NY1KO γM | NY1 | MiniLCRα2 miniLCRβS | γM | Hba0//Hba0‡ | Hbb0//Hbb01-153 |
| NY1KO γH | NY1 | MiniLCRα2 miniLCRβS | γH | Hba0//Hba0‡ | Hbb0//Hbb01-153 |
| BERK | BERK | MiniLCR α1GγAγδβS | — | Hba0//Hba0‡ | Hbb0//Hbb01-155 |
| BERK γM | BERK | MiniLCR α1GγAγδβS | γM | Hba0//Hba0‡ | Hbb0//Hbb01-155 |
Reticulocytes, red cell indices, and smears
Mice were bled from the tail (with a 2-hour recovery period under 40% oxygen) using protocols approved by the animal studies committee. Blood samples were analyzed for reticulocytes and red cell indices using the Sysmex SE 9000 system (Sysmex Corp of America, Long Grove, IL). Manual counts after staining with new methylene blue were used to validate the Sysmex reticulocyte counts in a limited number of cases, and good agreement was found. Blood smears were made from blood obtained from the tail, and dried, fixed, and stained with Giemsa. The mean corpuscular hemoglobin concentration was measured in plasma by measurement of hematocrit (MicroHematocrit, Damon/IEF Division, Needham Hights, MA) and hemoglobin concentration by diluting with Drabkins reagent and measuring the optical density at 540 nm.
High-performance liquid chromatography and chain synthesis
The globin composition was determined by high-performance liquid chromatography (HPLC) as previously described.22 For chain synthesis, 5 to 10 μL of washed and packed reticulocyte-enriched cells were obtained by Percoll-Larex centrifugation and added to 200 μL of the final 3H-leucine chain synthesis mix, incubated 3 hours in a shaking water bath at 37°C, and then washed and hemolyzed. Chain separation was achieved by adding 4 μL of the hemolysate to 400 μL of the HPLC starting buffer and performing reverse-phase HPLC as described above. Fractions were collected every minute and counted on an LKB 1215 Rackbeta liquid scintillation counter (Wallac Inc, Gaithersburg, MD). Reticulocyte incubation medium used: Fetal bovine serum (FBS) is dialyzed for 24 hours against Hanks balanced salt solution. The final medium: 0.5 mL FBS, 0.5 mL Dulbecco phosphate buffered saline (DPBS), 20 μL of a solution containing 1 mM of each of 19 amino acids (minus leucine), 10 μL of a 5 mg/mL solution of FeSO4.7H20, 2 mg/mL glucose, and 3.7 MBq (100 μCi) 3H-leucine.23 The percentage of newly synthesized chains was calculated by plotting counts per minute versus fraction number and determining the area under each peak. The percentage of newly synthesized γ-chains was calculated as a percentage of all β-like chains and compared with the percentage of all β-like chains determined by HPLC in peripheral blood.
2,3-Diphosphoglycerate and red cell density
Urine concentrating ability
Mice were deprived of water for 8 or 24 hours in a metabolic cage as indicated. Only female mice were used because it has been previously reported, and we have confirmed, that the urine concentrating ability of male and female C57BL mice is significantly different. At the end of this period, urine was collected onto Parafilm and the osmolarity was measured after a 1:10 dilution with distilled water using a Microosmette (Precision Systems, Natic, MA).
F-cell determination
Cells were stained for FACS analysis with a flouresceine isothiocyanate (FITC)-conjugated monoclonal antibody specific for human γ-globin (a kind gift from Dr Thomas Campbell, EG&G Wallac, a Perkin-Elmer Life Science Company, Akron, OH).
Histopathology
Two NY1KO γL mice (ages 35 and 51 days), 3 NY1KO γM mice (ages 44, 65, and 167 days), and 4 NY1KO γH mice (ages 87, 137, 148, and 172 days) were examined. Two BERK mice without γ (ages 69 and 169 days) and 2 BERK γM mice (83 and 164 days) were examined. Tissues were preserved in 10% buffered formalin. Slides were stained with hematoxylin and eosin and trichrome. One to 2 full-tissue sections per organ per animal were examined.
Results
High-performance liquid chromatography, reticulocytes, and red cell indices
Percentage HbF was measured both by HPLC and by chain synthesis and is presented in Table 2 and Figure 4. The percentage HbF in the NY1KO γL mice decreases with time, in contrast to NY1KO γM and γH mice, in which the percentage HbF increases with time, from a low point that occurs between 15 and 30 days of age to a plateau which is reached by about 60 days. The NY1KO γM mouse has a low value about 7% HbF that increases to about 20% by 60 days (a 3-fold increase), whereas the NY1KO γH mouse has a low value of about 27% that increases to about 40% by 60 days (a 1.5-fold increase). Unless otherwise noted measurements such as red cell indices and urine concentrating ability were made on mice that were 60 days of age or older.
Red cell indices of knockout mice
| No. . | . | N . | βS % . | αH % . | γ % 2 wk . | γ % >9 wk . | β/α ratio . | MCH pg/cell . | MCV fl . | MCHC g/dL* . | Retics % Sysmex . | Hct . |
|---|---|---|---|---|---|---|---|---|---|---|---|---|
| 1 | C57BL CONTROL | 20 | — | — | — | — | 0.93 | 14.5 ± 1.0 | 45.4 ± 0.9 | 33 ± 1.2 | 2.2 ± 0.5 | 48 ± 1 |
| 2 | C57BL Hbbth-1//Hbbth-1 | |||||||||||
| THAL | 6 | — | — | — | — | 0.79, 0.75†-0.78‡ | 12.7 ± 0.5 | 39.1 ± 1.9 | 24.9 ± 1.3 | 24.6 ± 3.3 | 32.3 ± 1.6 | |
| 3 | α2βSγ(F1352)Hba0//Hba0Hbb0//Hbb0 | |||||||||||
| NY1KO γL | 4 | 97 | 100 | 4 | <3 | 0.902-155 | 14.2 ± 1.12-155 | 57.3 ± 1.4 | 20.8 ± 1.9 | 63.2 ± 11.82-164 | 22.4 ± 1.32-a | |
| 4 | α2βSγ(G203)Hba0//Hba0Hbb0//Hbb0 | |||||||||||
| NY1KO γM | 10 | 80 | 100 | 7 | 20 | 0.932-155 | 13.7 ± 0.8# | 53.5 ± 1.9 | 24 ± 1.8 | 30.1 ± 9.62-154 | 34.0 ± 4.62-b,2-c | |
| 5 | α2βSγ(G100)Hba0//Hba0Hbb0//Hbb0 | |||||||||||
| NY1KO γH | 20 | 60 | 100 | 27 | 40 | 0.952-155 | 14.4 ± 0.52-155 | 49.3 ± 1.6 | 31 ± 1.9 | 12.9 ± 2.72-161 | 41.1 ± 4.02-d | |
| 6 | α1GγAγδβSHba0//Hba0Hbb0//Hbb0 | |||||||||||
| BERK | 20 | >99 | 100 | <1 | <1 | 0.82, 0.792-153 | 9.3 ± 1.0 | 42.1 ± 1.8 | 18.5 ± 1.4 | 36.5 ± 8.02-154 | 28.7 ± 4.02-e | |
| 7 | α1GγAγδβSγ(G203)Hba0//Hba0Hbb0//Hbb0 | |||||||||||
| BERK γM | 5 | 79 | 100 | 15 | 21 | 0.892-155 | 10.8 ± 1.52-160 | 43.6 ± 1.8 | 22.9 ± 1.8 | 37.2 ± 5.82-154 | 41.6 ± 4.02-f |
| No. . | . | N . | βS % . | αH % . | γ % 2 wk . | γ % >9 wk . | β/α ratio . | MCH pg/cell . | MCV fl . | MCHC g/dL* . | Retics % Sysmex . | Hct . |
|---|---|---|---|---|---|---|---|---|---|---|---|---|
| 1 | C57BL CONTROL | 20 | — | — | — | — | 0.93 | 14.5 ± 1.0 | 45.4 ± 0.9 | 33 ± 1.2 | 2.2 ± 0.5 | 48 ± 1 |
| 2 | C57BL Hbbth-1//Hbbth-1 | |||||||||||
| THAL | 6 | — | — | — | — | 0.79, 0.75†-0.78‡ | 12.7 ± 0.5 | 39.1 ± 1.9 | 24.9 ± 1.3 | 24.6 ± 3.3 | 32.3 ± 1.6 | |
| 3 | α2βSγ(F1352)Hba0//Hba0Hbb0//Hbb0 | |||||||||||
| NY1KO γL | 4 | 97 | 100 | 4 | <3 | 0.902-155 | 14.2 ± 1.12-155 | 57.3 ± 1.4 | 20.8 ± 1.9 | 63.2 ± 11.82-164 | 22.4 ± 1.32-a | |
| 4 | α2βSγ(G203)Hba0//Hba0Hbb0//Hbb0 | |||||||||||
| NY1KO γM | 10 | 80 | 100 | 7 | 20 | 0.932-155 | 13.7 ± 0.8# | 53.5 ± 1.9 | 24 ± 1.8 | 30.1 ± 9.62-154 | 34.0 ± 4.62-b,2-c | |
| 5 | α2βSγ(G100)Hba0//Hba0Hbb0//Hbb0 | |||||||||||
| NY1KO γH | 20 | 60 | 100 | 27 | 40 | 0.952-155 | 14.4 ± 0.52-155 | 49.3 ± 1.6 | 31 ± 1.9 | 12.9 ± 2.72-161 | 41.1 ± 4.02-d | |
| 6 | α1GγAγδβSHba0//Hba0Hbb0//Hbb0 | |||||||||||
| BERK | 20 | >99 | 100 | <1 | <1 | 0.82, 0.792-153 | 9.3 ± 1.0 | 42.1 ± 1.8 | 18.5 ± 1.4 | 36.5 ± 8.02-154 | 28.7 ± 4.02-e | |
| 7 | α1GγAγδβSγ(G203)Hba0//Hba0Hbb0//Hbb0 | |||||||||||
| BERK γM | 5 | 79 | 100 | 15 | 21 | 0.892-155 | 10.8 ± 1.52-160 | 43.6 ± 1.8 | 22.9 ± 1.8 | 37.2 ± 5.82-154 | 41.6 ± 4.02-f |
Mean ± SD. The statistics were calculated using the program StatGraphics.
Determined by hand-spun hematocrit and Drabkin hemoglobin, note that the very high reticulocyte counts will result in abnormally low MCHCs.
Skow et al.26
Sauvage et al.27
Pàszty et al.13
Not statistically different from C57BL.
Not statistically different versus each other in same column.
#4 versus 5 P < .02.
6 versus 7 P < .05.
3 versus 4 P < .01.
4 versus 5 P < .002.
3 versus 4 P < .01.
4 versus 5 P < .01.
4 versus 6 P < .05.
5 versus 7 not statistically different.
6 versus 7 P < .001.
C57BL versus 5 or 7 P < .02.
Low hematocrits and high reticulocyte counts are associated with rapid red cell destruction and greater hematologic severity in humans. As HbF increases in mature NY1KO mice from less than 3% to 20% to 40% for γL, γM, and γH mice, respectively, the reticulocyte count decreases from 63% to 30% to 13% respectively (Table 2). Hematocrit similarly increases from 22 to 34 to 41 for the same series. For BERK mice, as γ increases from less than 1% to 21% for BERK and BERK γM mice, reticulocyte counts remain constant at 37% and hematocrit increases from 29 to 42. Note the very low MCH of the BERK mouse (9.3 pg/cell) and that, even after γM was introduced and substantially corrected chain synthesis imbalance, it is still less (10.8 pg/cell) than the MCH of thalassemic mice (12.7 pg/cell).
Chain synthesis and comparison of βS production between NY1 and BERK mice
The results of chain synthesis experiments are given in Table 2. The ratio of all β-like chains to all α-like chains was measured for C57BL, NY1KO γL, NY1KO γM, NY1KO γH, and BERK γM and was found to be within the normal range for all 5 types of mouse (β/α ratio of 0.93 ± 0.03). The β/α ratios for THAL and BERK mice determined in this laboratory (0.79 and 0.82, respectively) compared favorably with literature values (0.75-0.7826,27 and 0.79,13 respectively).
Another way of looking at globin production is to breed BERK and NY1KO mice to a third transgenic and use HPLC to measure the ratio of βA to βS. The result of such breeding is NY1KO γM × αβA-KO yields some mice with no γ, 100% human α, and 50% each of βA and βS. BERK × αβA-KO yields some mice with 100% human α, 75% βA and 25% βSwhere αβA-KO is a mouse with miniLCRαβAHba0//Hba0 Hbb0//Hbb0obtained from Ramesh Kumar (formerly of DNX, Plainsborough, NJ). In this competition, the NY1 transgene produces twice as much βS as the BERK transgene.
2,3-diphosphoglycerate
When deoxygenated HbS is exposed to elevated 2,3-DPG, oxygen affinity is decreased and polymer formation increases.28Thus, elevated 2,3-DPG can increase the tendency to form polymer and potentially increase the frequency of vaso-occlusion. Mice have a higher level of 2,3-DPG than humans. Average values for human 2,3-DPG is about 10 to 15 μg/pg Hb. All mice, including the transgenic mice examined have elevated 2,3-DPG (an average of 31 ± 1.5 μg/pg Hb for C57BL and 25.5 ± 3.0 μg/pg Hb for the transgenics studied).
Red cell density
Within the range (less than a factor of 3 in hemoglobin concentration) and accuracy of these measurements, red cell density is directly proportional to the intracellular hemoglobin concentration or MCHC.29 Density gradients therefore provide a means of visualizing the distribution of MCHCs present in whole blood. This is particularly important in sickle cell disease because the density distribution may be not only broad (as reflected in red cell distribution width [RDW]), but is also frequently asymmetric. The presence of very dense cells, seen in NY1KO γM in Figure1, is a hallmark of sickle cell disease. The black line can be used to highlight the difference in density distribution between NY1KO γM and BERK mice.
Percoll Larex continuous density gradient of the 5 types of transgenic mice.
The lightest cells (at the top of the gradient) are predominantly reticulocytes and the densest cells (at the bottom of the gradient) are enriched in ISCs. The MCHC found at each depth in the tube is displayed on the left hand side of the gradients. The gradient has physiologic pH and osmolarity and is performed at 37°C. From left to right: density-marker beads, C57BL, NY1KO γL, NY1KO γM, NY1KO γH, BERK, and BERK γM. Note the highest density (MCHC) cells in the NY1KO γM mouse and the lowest density (MCHC) cells in the BERK mouse. The horizontal black line is included for reference: note in particular that about 40% of the NY1KO γL red cells have a density greater than that indicated by the line, more than 90% of NY1KO γM red cells have a density greater than that indicated by the line, and that less than 10% of the BERK red cells have a density greater than that indicated by the line. All 3 NY1KO mice have a fraction of cells lighter than the C57 mouse that are predominantly reticulocytes and appear in proportion to the percentage reticulocytes: 63% reticulocytes for NY1KO γL (less than 3% γ), 30% reticulocytes for the NY1KO γM (20% γ), and 13% for the NY1KO γH (40% γ). The percentage high-density cells is greater in the NY1KO γM mouse with 20% γ. In contrast, the BERK mouse12 has very few red cells with a density equal to or greater than the C57 red cells. When γM is introduced into the BERK mouse, red cell density increases resulting in more cells with a nearly normal MCHC; note that, in contrast to the BERK mouse, more than 90% of the red cells have a density greater than that indicated by the black line. Separation of the gradient of the BERK γM mouse into a top and bottom fraction shows that there is a higher percentage γ in the bottom fraction.
Percoll Larex continuous density gradient of the 5 types of transgenic mice.
The lightest cells (at the top of the gradient) are predominantly reticulocytes and the densest cells (at the bottom of the gradient) are enriched in ISCs. The MCHC found at each depth in the tube is displayed on the left hand side of the gradients. The gradient has physiologic pH and osmolarity and is performed at 37°C. From left to right: density-marker beads, C57BL, NY1KO γL, NY1KO γM, NY1KO γH, BERK, and BERK γM. Note the highest density (MCHC) cells in the NY1KO γM mouse and the lowest density (MCHC) cells in the BERK mouse. The horizontal black line is included for reference: note in particular that about 40% of the NY1KO γL red cells have a density greater than that indicated by the line, more than 90% of NY1KO γM red cells have a density greater than that indicated by the line, and that less than 10% of the BERK red cells have a density greater than that indicated by the line. All 3 NY1KO mice have a fraction of cells lighter than the C57 mouse that are predominantly reticulocytes and appear in proportion to the percentage reticulocytes: 63% reticulocytes for NY1KO γL (less than 3% γ), 30% reticulocytes for the NY1KO γM (20% γ), and 13% for the NY1KO γH (40% γ). The percentage high-density cells is greater in the NY1KO γM mouse with 20% γ. In contrast, the BERK mouse12 has very few red cells with a density equal to or greater than the C57 red cells. When γM is introduced into the BERK mouse, red cell density increases resulting in more cells with a nearly normal MCHC; note that, in contrast to the BERK mouse, more than 90% of the red cells have a density greater than that indicated by the black line. Separation of the gradient of the BERK γM mouse into a top and bottom fraction shows that there is a higher percentage γ in the bottom fraction.
Red cell morphology
When the red cell morphology of the NY1KO γM and γH mice is compared with the BERK mice (Figure 2), we find results that are in agreement with the Percoll-Larex continuous density gradients (Figure 1).
Morphology of red cells from C57BL, NY1KO γH, NY1KO γM, and BERK mice.
(A), C57BL; (B), NY1KO γH; (C), NY1KO γM; and (D), BERK mice. Note that the NY1KO γH mouse red cells are hyperchromic when compared with C57BL, and the BERK mouse red cells are hypochromic (open arrows). Solid arrows indicate circulating irreversibly sickled cells (ISCs) that can be found in all 3 types of transgenic mice. The red cells of the NY1KO γH mouse are normochromic or hyperchromic when compared with the control C57BL mouse and, in contrast, the red cells of the BERK mouse are severely hypochromic when compared with the C57BL mouse. These results are in agreement with the Percoll-Larex continuous density gradients (Figure 1), which show that the BERK mice have a much lower MCHC than either NY1KO γM or γH mice. This is particularly apparent when the BERK mice are compared with the NY1KO γM mice that have approximately the same average reticulocyte counts.
Morphology of red cells from C57BL, NY1KO γH, NY1KO γM, and BERK mice.
(A), C57BL; (B), NY1KO γH; (C), NY1KO γM; and (D), BERK mice. Note that the NY1KO γH mouse red cells are hyperchromic when compared with C57BL, and the BERK mouse red cells are hypochromic (open arrows). Solid arrows indicate circulating irreversibly sickled cells (ISCs) that can be found in all 3 types of transgenic mice. The red cells of the NY1KO γH mouse are normochromic or hyperchromic when compared with the control C57BL mouse and, in contrast, the red cells of the BERK mouse are severely hypochromic when compared with the C57BL mouse. These results are in agreement with the Percoll-Larex continuous density gradients (Figure 1), which show that the BERK mice have a much lower MCHC than either NY1KO γM or γH mice. This is particularly apparent when the BERK mice are compared with the NY1KO γM mice that have approximately the same average reticulocyte counts.
Urine concentrating ability
Urine concentrating ability after either 8 or 24 hours water deprivation is given in Table 3. We find that the BERK mouse without HbF and the NY1KO γM mouse have low urine concentrating ability that suggests either chronic renal damage or red cell interference with urine concentrating ability by sickled cells. Normal urine concentrating ability is found in the NY1KO γH with 40% HbF mouse and the BERK γM mouse with only 20% HbF.
Urine concentrating ability in sickle transgenic mice
| . | βS % . | αH% . | γ% >9 wk . | Urine concentrate (mOsm) . |
|---|---|---|---|---|
| C57BL | 3147 ± 6533-150 | |||
| CONTROL | — | — | — | 1688 ± 2333-151 |
| C57BL Hbbth-1//Hbbth-1 | ||||
| THAL | — | — | — | 2820 ± 4053-150 |
| α2βSγ(G203)Hba0//Hba0Hbb0//Hbb0 | ||||
| NY1KO γM | 80 | 100 | 20 | 1176 ± 1273-151b |
| α2βSγ(G100)Hba0//Hba0Hbb0//Hbb0 | ||||
| NY1KO γH | 60 | 100 | 40 | 3285 ± 3683-150,3-a |
| α1GγAγδβSHba0//Hba0Hbb0//Hbb0 | ||||
| BERK | >99 | 100 | <1 | 898 ± 2263-151b |
| α1GγAγδβSγ(G203)Hba0//Hba0Hbb0//Hbb0 | ||||
| BERK γM | 79 | 100 | 21 | 1710 ± 4743-151,3-a |
| . | βS % . | αH% . | γ% >9 wk . | Urine concentrate (mOsm) . |
|---|---|---|---|---|
| C57BL | 3147 ± 6533-150 | |||
| CONTROL | — | — | — | 1688 ± 2333-151 |
| C57BL Hbbth-1//Hbbth-1 | ||||
| THAL | — | — | — | 2820 ± 4053-150 |
| α2βSγ(G203)Hba0//Hba0Hbb0//Hbb0 | ||||
| NY1KO γM | 80 | 100 | 20 | 1176 ± 1273-151b |
| α2βSγ(G100)Hba0//Hba0Hbb0//Hbb0 | ||||
| NY1KO γH | 60 | 100 | 40 | 3285 ± 3683-150,3-a |
| α1GγAγδβSHba0//Hba0Hbb0//Hbb0 | ||||
| BERK | >99 | 100 | <1 | 898 ± 2263-151b |
| α1GγAγδβSγ(G203)Hba0//Hba0Hbb0//Hbb0 | ||||
| BERK γM | 79 | 100 | 21 | 1710 ± 4743-151,3-a |
Mean ± SD. The statistics were calculated using the program StatGraphics.
24-hour water deprivation.
8-hour water deprivation.
Not statistically different from C57BL; b,P < .01 versus C57BL.
F-cell determination and γ levels
Non–F cells (cells with no HbF) and F cells (cells with HbF) are a characteristic of human sickle cell disease. NY1KO γM mice have F cells that can be readily detected by FACS analysis (Figure3). F cells in these mice increased between day 20 and day 40 in parallel with the increase in the percentage γ-globin (Figure 4). BERK γM mice also have F cells. NY1KO γH mice have a pan-cellular distribution of HbF; that is, there is HbF in all cells.
Comparison of distribution of γ in red cells of by FACS analysis using FITC-labeled antibody specific for human γ globin.
Left panels, fluorescence intensity (FL1) versus cell size (which is proportional to fluorescent side scatter, FSC); right panels, number of cells versus fluorescence intensity. The same arbitrary scale is used in all 3 graphs for both FL1 and FSC. (A), NY1KO γM; (B), NY1KO γH; and (C), BERK γM mice. Note the presence of 2 populations of red cells, one expressing γ (high fluorescence intensity) and one not, in NY1KO γM and BERK γM mice and the small red cell size in the BERK γM mice both in cells with and without γ relative to the NY1KO mice. The small relative size of BERK mice is compatible with the MCVs given in Table 2.
Comparison of distribution of γ in red cells of by FACS analysis using FITC-labeled antibody specific for human γ globin.
Left panels, fluorescence intensity (FL1) versus cell size (which is proportional to fluorescent side scatter, FSC); right panels, number of cells versus fluorescence intensity. The same arbitrary scale is used in all 3 graphs for both FL1 and FSC. (A), NY1KO γM; (B), NY1KO γH; and (C), BERK γM mice. Note the presence of 2 populations of red cells, one expressing γ (high fluorescence intensity) and one not, in NY1KO γM and BERK γM mice and the small red cell size in the BERK γM mice both in cells with and without γ relative to the NY1KO mice. The small relative size of BERK mice is compatible with the MCVs given in Table 2.
Percentage γ versus mouse age for 3 different types of mice.
Filled circles, percentage γ/all β-like chains by HPLC; triangles, percentage F-cells by FACS; squares, percentage γ by chain synthesis. Mice older than 180 days are plotted as 172 to 178 days; in this range, there was no correlation between percent HbF and age. Note that γ increases with age in all mice, but that the percentage γ/all β-like chains as measured by chain synthesis for NY1KO γM does not increase with age. The most dramatic changes in percentage γ occurred in mice with F-cells (both lines of mice expressing γM; bottom 2 panels). The largest difference between γ as measured by chain synthesis and by HPLC in peripheral blood was found in mice with F-cells. The increase in percentage γ in whole blood over percentage γ as measured by chain synthesis is due to increased survival of F-cells.
Percentage γ versus mouse age for 3 different types of mice.
Filled circles, percentage γ/all β-like chains by HPLC; triangles, percentage F-cells by FACS; squares, percentage γ by chain synthesis. Mice older than 180 days are plotted as 172 to 178 days; in this range, there was no correlation between percent HbF and age. Note that γ increases with age in all mice, but that the percentage γ/all β-like chains as measured by chain synthesis for NY1KO γM does not increase with age. The most dramatic changes in percentage γ occurred in mice with F-cells (both lines of mice expressing γM; bottom 2 panels). The largest difference between γ as measured by chain synthesis and by HPLC in peripheral blood was found in mice with F-cells. The increase in percentage γ in whole blood over percentage γ as measured by chain synthesis is due to increased survival of F-cells.
Histopathology
We compared liver, kidney, and spleen for each series of mice: the NY1KO and BERK mice (Table 4). Some comments apply to both series and all levels of HbF. In the liver, geographic lobular necrosis is observed consistent with ischemia (vascular infarction); pericentral necrosis and fibrosis are observed and are consistent with venous congestion. Hematopoiesis was most marked in NY1KO γL mice and necrosis was most severe in NY1KO γM mice. The spleens of all animals of both series and with all levels of HbF were grossly enlarged (Table5), highly erythropoietic, and contained iron pigment, which is consistent with rapid red cell destruction and replacement. The number of animals in each group was relatively small (2 to 4), and animals of different ages were present in these small groups. One of the most striking observations was that there were no pathology-free animals in any of the 4 NY1KO γH (the highest level of γ) mice, underscoring the enhanced severity of sickle cell disease in mice.
Pathology of mice expressing exclusively HbS and human γ-chains
| . | NY1KO + γL . | NY1KO + γM . | NY1KO + γH . | BERK . | BERK + γM . |
|---|---|---|---|---|---|
| HbF/retics | >3% γ/63% retics | 20% γ/30% retics | 40% γ/13% retics | >1% γ/37% retics | 21% γ/37% retics |
| Spleen | Congestive splenomegaly 2/2 Fe 2/2 Slight fibrosis 2/2 | Congestive splenomegaly 3/3 Fe 2/3 Fibrosis 2/3 | Congestive splenomegaly 4/4 Fe 3/4 Focal necrosis 2/4 | Congestive splenomegaly 2/2 Fe 2/2 Fibrosis 2/2 | Congestive splenomegaly 2/2 Fe 2/2 Organizing infarct 1/2 |
| Liver | Hematopoiesis 2/2 Sinusoids packed 2/2 Mild necrosis 1/2 Central vein dilated 1/2 | Moderate hematopoiesis 3/3 Sinusoids packed 1/3 Necrosis/fibrosis 3/3 Central vein dilated 1/3 | Little hematopoiesis 4/4 Moderate congestion 2/4 Focal necrosis 3/4 Central vein dilated 1/4 Fe in Kupfer cells 1/4 | Moderate hematopoiesis 2/2 Severe congestion 2/2 Necrosis 2/2 | Hematopoiesis 2/2 Moderate congestion 2/2 Small areas of necrosis 1/2 Fe in Kupfer cells 2/2 |
| Kidney | Medullary congestion 2/2 Focal hypercellular glomeruli 2/2 Tubular atrophy 1/2 Proliferating epithelial cells 1/2 | Congestion 2/3 Distended glomeruli 2/3 Fe tubules/cortex 1/3 Scarring cortex 2/3 | Mild congestion 2/4 Atrophy 1/4 Focal scarring 2/4 Minimal fibrosis 2/4 Microcysts 1/4 | Medullary congestion 2/2 Congested glomeruli 2/2 Scarring cortex 2/2 | Mild congestion 2/2 Hypercellular glomeruli 2/2 Tubular degeneration 1/2 Fe 1/2 |
| Brain | Normal | Pycnotic Purkinje 2/3 Lacunae 1/3 Scarring 1/3 Autolytic area 1/3 | Normal | Purkinje intact 2/2 Some scarring 1/2 Packed vessels 1/2 | Congested 1/2 |
| Heart | Hypertrophy 1/2 Focal right ventricular interstitial fibrosis 1/2 | Right/left hypertrophy 2/3 Scarring 1/3 | Perivascular fibrosis 1/4 Left atrial thrombosis 1/4 | Right/left hypertrophy 2/2 Mild fibrosis 1/2 | Right ventricular hypertrophy 1/2 |
| Age (d) | 35, 51 Note very young age | 44, 65, 167 Oldest most severe | 87, 137, 148, 172 | 69, 169 | 83, 164 |
| . | NY1KO + γL . | NY1KO + γM . | NY1KO + γH . | BERK . | BERK + γM . |
|---|---|---|---|---|---|
| HbF/retics | >3% γ/63% retics | 20% γ/30% retics | 40% γ/13% retics | >1% γ/37% retics | 21% γ/37% retics |
| Spleen | Congestive splenomegaly 2/2 Fe 2/2 Slight fibrosis 2/2 | Congestive splenomegaly 3/3 Fe 2/3 Fibrosis 2/3 | Congestive splenomegaly 4/4 Fe 3/4 Focal necrosis 2/4 | Congestive splenomegaly 2/2 Fe 2/2 Fibrosis 2/2 | Congestive splenomegaly 2/2 Fe 2/2 Organizing infarct 1/2 |
| Liver | Hematopoiesis 2/2 Sinusoids packed 2/2 Mild necrosis 1/2 Central vein dilated 1/2 | Moderate hematopoiesis 3/3 Sinusoids packed 1/3 Necrosis/fibrosis 3/3 Central vein dilated 1/3 | Little hematopoiesis 4/4 Moderate congestion 2/4 Focal necrosis 3/4 Central vein dilated 1/4 Fe in Kupfer cells 1/4 | Moderate hematopoiesis 2/2 Severe congestion 2/2 Necrosis 2/2 | Hematopoiesis 2/2 Moderate congestion 2/2 Small areas of necrosis 1/2 Fe in Kupfer cells 2/2 |
| Kidney | Medullary congestion 2/2 Focal hypercellular glomeruli 2/2 Tubular atrophy 1/2 Proliferating epithelial cells 1/2 | Congestion 2/3 Distended glomeruli 2/3 Fe tubules/cortex 1/3 Scarring cortex 2/3 | Mild congestion 2/4 Atrophy 1/4 Focal scarring 2/4 Minimal fibrosis 2/4 Microcysts 1/4 | Medullary congestion 2/2 Congested glomeruli 2/2 Scarring cortex 2/2 | Mild congestion 2/2 Hypercellular glomeruli 2/2 Tubular degeneration 1/2 Fe 1/2 |
| Brain | Normal | Pycnotic Purkinje 2/3 Lacunae 1/3 Scarring 1/3 Autolytic area 1/3 | Normal | Purkinje intact 2/2 Some scarring 1/2 Packed vessels 1/2 | Congested 1/2 |
| Heart | Hypertrophy 1/2 Focal right ventricular interstitial fibrosis 1/2 | Right/left hypertrophy 2/3 Scarring 1/3 | Perivascular fibrosis 1/4 Left atrial thrombosis 1/4 | Right/left hypertrophy 2/2 Mild fibrosis 1/2 | Right ventricular hypertrophy 1/2 |
| Age (d) | 35, 51 Note very young age | 44, 65, 167 Oldest most severe | 87, 137, 148, 172 | 69, 169 | 83, 164 |
Organ weights as percentage of body weight for mice expressing exclusively human hemoglobins
| Mouse . | γ % >9 wk . | Age (d) . | Liver . | Spleen . | Kidney single . | Heart . |
|---|---|---|---|---|---|---|
| C57BL | — | 135 ± 30 | 4.8 ± 0.8 | 0.26 ± 0.04 | 0.57 ± 0.03 | 0.48 ± 0.09 |
| NY1KOγL | <3 | 43 ± 8 | 7.4 ± 0.3 | 3.7 ± 0.4 | 0.8 ± 0.02 | 0.78 ± 0.04 |
| NY1KOγM | 20 | 116 ± 51 | 7.0 ± 2.1 | 5.3 ± 0.6 | 1.3 ± 0.4 | 0.79 ± 0.04 |
| NY1KOγH | 40 | 124 ± 26 | 6.4 ± 0.5 | 1.3 ± 0.3 | 0.9 ± 0.2 | 0.67 ± 0.12 |
| BERK | <1 | 94 ± 35 | 8.2 ± 0.8 | 8.6 ± 1.3 | 1.0 ± 0.2 | 0.87 ± 0.15 |
| BERKγM | 21 | 124 ± 41 | 5.8 ± 0.8 | 7.5 ± 1.5 | 1.0 ± 0.2 | 0.9 ± 0.06 |
| Mouse . | γ % >9 wk . | Age (d) . | Liver . | Spleen . | Kidney single . | Heart . |
|---|---|---|---|---|---|---|
| C57BL | — | 135 ± 30 | 4.8 ± 0.8 | 0.26 ± 0.04 | 0.57 ± 0.03 | 0.48 ± 0.09 |
| NY1KOγL | <3 | 43 ± 8 | 7.4 ± 0.3 | 3.7 ± 0.4 | 0.8 ± 0.02 | 0.78 ± 0.04 |
| NY1KOγM | 20 | 116 ± 51 | 7.0 ± 2.1 | 5.3 ± 0.6 | 1.3 ± 0.4 | 0.79 ± 0.04 |
| NY1KOγH | 40 | 124 ± 26 | 6.4 ± 0.5 | 1.3 ± 0.3 | 0.9 ± 0.2 | 0.67 ± 0.12 |
| BERK | <1 | 94 ± 35 | 8.2 ± 0.8 | 8.6 ± 1.3 | 1.0 ± 0.2 | 0.87 ± 0.15 |
| BERKγM | 21 | 124 ± 41 | 5.8 ± 0.8 | 7.5 ± 1.5 | 1.0 ± 0.2 | 0.9 ± 0.06 |
All values are mean ± standard deviation. For spleen and kidney, the organ weights of all transgenic mice are statistically greater than those of C57BL; but the differences between different types of transgenic mice are, for the most part, not statistically significant.
In the liver, NY1KO γL mice had severe congestion, moderate hematopoiesis, focal areas of necrosis; NY1KO γM mice had moderate-to-severe congestion, mild-to-moderate hematopoiesis, extensive necrosis with fibrosis and elevated Fe++; and NY1KO γH mice had active hematopoiesis, multiple foci of necrosis, and elevated Fe++. In the kidney, NY1KO γL mice had medullary congestion, focal glomerular hypercellularity, and focal interstitial fibrosis; NY1KO γM mice had mild congestion, focal hypercellular glomeruli, mild-to-severe interstitial fibrosis, and focally elevated Fe++; and NY1KO γH mice had focal cortical scarring, interstitial fibrosis and one case of tubular atrophy. In the spleen, NY1KO γL mice had congestion, minimal fibrosis, and Fe++ pigment; NY1KO γM mice had severe congestion, minimal-to-mild fibrosis, and elevated Fe++; and NY1KO γH mice had mild-to-moderate congestion, mild fibrosis, and elevated Fe++. In the liver, BERK mice had severe congestion, mild-to-marked erythropoisis, mild-to-severe necrosis, fibrosis, and elevated Fe++; and BERK γM mice had moderate congestion, hematopoiesis, pericentral fibrosis, and elevated Fe++. In the kidney, BERK mice had focal cortical and medullary scarring and interstitial fibrosis; and BERK γM mice had medullary congestion, focal glomerular hypercellularity, and focal cortical scarring. In the spleen, BERK mice had severe congestion, mild fibrosis, and elevated Fe++; and BERK γM mice had mild congestion, focal necrosis, fibrosis, and elevated Fe++.
Discussion
Formation of rigid polymers of deoxy HbS inside the sickle red cell result in nondeformable red cells that may block the microcirculation and undergo increased red cell destruction. The presence of fetal hemoglobin (HbF, α2γ2) efficiently prevents polymer formation and exerts a strong protective effect in sickle cell patients both on the red cell and in prevention of end-organ damage.
Transgenic mice expressing exclusively human hemoglobins developed in our laboratory (NY1KO mice) and BERK mice have severe pathology characteristic of human sickle cell disease that is ameliorated by HbF. However, less HbF is required to reduce pathology in the BERK model which we attribute, at least in part, to its thalassemic phenotype.
Pathology of NY1KO and BERK mice
Both the NY1KO and the BERK mouse with low levels of adult HbF expression have severe pathology characteristic of sickle cell disease that includes reticulocytosis, anemia, loss of urine concentrating ability, splenomegaly, erythroid hyperplasia in bone marrow, liver damage characteristic of ischemia, iron deposition, and evidence of chronic organ damage in multiple tissues. All the mice described here are protected by high levels of HbF expression during the fetal period.
The NY1KO and the BERK models differ in MCH (which is low in thalassemia) and the ratio of newly synthesized β- and α-globin chains (which is 0.8 or less for β-thalassemia). NY1KO mice have normal-to-near normal values for both MCH and the β/α ratio for chain synthesis. In contrast, the BERK mouse has low MCH and a β/α ratio similar to that seen in THAL mice.
Both of these models, as well as those described by Ryan et al14 and Chang et al,15 are suitable for the study of pathology associated with sickle cell disease; however, the BERK and the Chang models have some characteristics of β-thalassemia that may affect not only red cells, but also other organs. For example, the simultaneous presence of β-thalassemic–like characteristics and HbS that may result in an environment that is highly susceptible to oxidative damage, because both syndromes are associated with free radical production. Only one of the Ryan models has been characterized for β/α synthesis ratio, and neither MCH nor MCHC were published for the remaining mice.
HbF improves reticulocyte count, hematocrit and renal dysfunction in both NY1KO and BERK mice
Increased HbF in sickle cell patients is associated with amelioration of disease and a similar effect is seen in both the NY1KO and the BERK models. Progressive increase in HbF expression in NY1KO γL, γM, and γH mice is correlated with a large progressive increase in hematocrit and a large progressive decrease in reticulocyte count (Table 2); however, neither hematocrit nor reticulocyte counts return to the values of C57BL mice.
Although NY1KO γH mice have reduced pathology and organ weights, these values also do not return to those seen in C57BL mice. In contrast, in NY1KO γH mice, urine concentrating ability is completely corrected. These observations suggest that HbF significantly ameliorates many aspects of pathology and that renal dysfunction is more sensitive to HbF than other properties.
When γM is bred into the BERK mouse, the hematocrit is significantly normalized and the urine concentrating defect is corrected, but reticulocyte count, spleen size, and other organ sizes remain high. BERK γM mice have F-cells and, as in human sickle cell patients and NY1KO γM mice, amelioration is observed even when HbF is heterogeneously distributed. Once again we find that renal dysfunction is more sensitive to HbF than other properties.
The effect of HbF in these transgenic mice is larger and more consistent than that observed in human disease where the ameliorative effects of HbF are partially obscured by diverse epistatic effects present in the human population.
Age dependence of HbF and F cells
F-cell enrichment (percentage of F cells higher than percentage of F reticulocytes) occurs in sickle cell disease because HbF reduces the probability of red cell destruction. In NY1KO γM mice, the age-related increase in HbF probably results from at least 2 factors: (1) selective survival of F cells and (2) increased synthesis of γ-chains. Chain synthesis was measured at 40 and 140 days in NY1KO γM mice. At both data points, the percentage γ-chains by chain synthesis was twice that measured in young mice by HPLC, indicating increased γ-chain synthesis; and, the percentage HbF in peripheral blood by HPLC was significantly higher than the percentage measured by chain synthesis, which implies preferential survival of F cells. FACS-detectable F cells in NY1KO γM mice increase with the age in tandem with the increase in the percentage HbF in peripheral blood. In contrast, the percentage HbF found by chain synthesis in NY1KO γH mice is the same as that measured by HPLC in peripheral blood. This is consistent with the pan-cellular distribution of HbF demonstrated by FACS. When γM is expressed in BERK mice, heterocellular expression of HbF with formation of F cells also occurs and an increase in HbF with age is also observed.
The presence of F cells does not completely explain the increase in HbF with age. While in utero, mice do not have a high-oxygen affinity hemoglobin such as HbF, but instead have low production of 2,3-DPG that reaches adult levels at about 3 weeks of age.30 We speculate that low 2,3-DPG (an antisickling condition) results in reduced destruction of non–F cells during the first 2 to 3 weeks of life, both in marrow before release and as reticulocytes in peripheral blood, which may partially account for low neonatal levels of HbF.
The efficacy of HbF is not the same in the NY1KO mouse and the BERK mouse
In both the BERK and the NY1KO models, hematologic and physiologic pathology are reduced in proportion to expression of HbF. However, if we compare reticulocyte count, hematocrit, and urine concentrating ability, NY1KO γM mice are most comparable to BERK mice; and BERK γM mice are most comparable with NY1KO γH mice. To understand why BERK mice with less HbF have reduced pathology compared with NY1KO mice with more HbF, we need to examine the impact of thalassemia on MCHC and, in turn, the impact of red cell MCHC on red cell survival and renal function.
Thalassemia in the BERK mouse
The BERK mouse has an imbalance in chain synthesis (Table 2 and Pàszty et al13) similar to that observed for THAL mice. In THAL mice, the hematologic consequences (reticulocytes 25%, Hct 32) are less severe than those reported for the BERK mouse (reticulocytes 37%, Hct 29). The THAL mouse does not have a urine concentrating defect; therefore the very significant urine concentrating defect, as well as the excess changes in reticulocyte count and hematocrit seen in the BERK mouse, can be ascribed to the presence of sickle hemoglobin.
Another way of evaluating globin production is to breed the BERK and the NY1KO mice to a third knockout transgenic and measure the percentage βS produced. The offspring express exclusively human hemoglobin, but the progeny of the NY1KO mice produce twice as much βS as those of the BERK mice, indicating deficient βS production in BERK mice. Therefore, both chain synthesis and these breeding experiments indicate that the consequences of thalassemia and its correction must be considered when HbF is introduced into the BERK mouse.
MCHC and red cell density profiles
MCHC plays a crucial role in the pathophysiology of sickle cell disease because the delay time for polymer formation is inversely proportional to the 30th power (and to the 15th power when nonideality effects are removed) of the concentration of deoxy HbS.31The extent of polymer formation is directly related to the concentration of deoxy HbS.
Sickle mice with low MCH and MCHC are partially protected from polymer formation. Sickle cell disease patients have red cells with a wide range of MCHCs32-34 that can be visualized by density gradient.33 The transgenic mice described here have a similar density pattern (Figure 1).
Most sickle transgenic mice have elevated MCHC when compared with C57BL. This is largely due to the deoxygenation-stimulated potassium efflux that is unique to patients with sickle cell disease35 and to transgenic mice expressing βS.36 The red cells of all forms of human sickle cell disease have either normal or elevated MCHC; therefore mice with low MCHC do not accurately represent the human condition. We have previously shown that inhibition of polymerization by introduction of γ-chains into αHβSβDD] mice restores the density profile to that of C57BL.37 A similar effect can be seen when NY1KO γM and NY1KO γH mice are compared; the number of high-density cells are reduced in NY1KO γH mice compared with NY1KO γM mice and, at the same time, the number of light cells (reticulocytes) are also reduced because of decreased red cell destruction. In contrast, in BERK mice, the introduction of HbF increases red cell density because the founder mice have abnormally low production of hemoglobin and thalassemia. The first effect of HbF is to restore normal MCH, balanced chain synthesis, and increase MCHC. Hence, the confounding effect of HbF in BERK mice: increased HbF both inhibits polymerization and, by raising the MCHC, favors polymerization.
The impact of MCHC on the relative amount of HbF required to ameliorate pathology of NY1KO and BERK mice
Density gradients demonstrate that most of the red cells of the BERK mouse have lower red cell density than those of NY1KO γM mouse. This implies that most of the red cells in NY1KO γM mice have a higher MCHC than most of the red cells of BERK mice. Measurement of average MCHC confirms a difference of 5.5 g/dL (in agreement with the density gradient), which, in turn, implies that red cells from NY1KO γM mice will have shorter delay times, more polymer formation, and produce more vaso-occlusion. Hence, it is not surprising that more HbF is required to effect a significant improvement in NY1KO γM mice in selected aspects of pathology, such as urine concentrating defect or hematocrit (40% HbF for the NY1KO series versus 20% HbF for the BERK series). This observation implies that, just as in human sickle cell disease, secondary features such as thalassemia in the mouse models or α-thalassemia in human patients will affect the amount of HbF required to ameliorate pathology.
The very high reticulocyte count of NY1KO γL and BERK mice is most likely because the increase in red cell density (MCHC) associated with both maturation and oxy/deoxy cycling results in subsequent removal of high-density cells from circulation via sickling-related processes. This hypothesis is supported by the enrichment of F cells in NY1KO γM mice in which non–F cells (that have a hemoglobin composition similar to NY1KO γL) are selectively removed from circulation, leaving primarily F-cells that are partially protected from polymerization by HbF.
HbF is in the range of 15% to 20% in some sickle cell and Sβo thalassemia patients, and these patients have a reduction in reticulocyte count38 without a return to normal levels. Most sickle cell patients, like some of the mice described here, have heterogeneous distribution of HbF and even at 20% HbF the disease is ameliorated but not abolished.
Conclusions
NY1KO and BERK mice with low HbF have severe pathology characteristic of sickle cell disease. However, BERK mice have low MCH and a thalassemia-like β/α ratio of chain synthesis.
Pathology in both the NY1KO and BERK models is progressively ameliorated by HbF. However, introduction of HbF does not have the same effect on all measures of pathology; urine concentrating effect appears to be the most sensitive to HbF of those tested here. Furthermore, introduction of HbF does not have the same effect on all mouse models; because of lower MCHC, the BERK mouse exhibits amelioration at lower levels of HbF than the NY1KO mouse.
The NY1KO mouse has 2 features that bring it closer to the human disease: (1) it has balanced chain synthesis and normal MCH at 3 different levels of HbF, and (2) the NY1KO γM mouse has F cells, another feature of human sickle cell disease, which have preferential survival and should be a sensitive marker of destruction of non–F cells.
The NY1KO γL mouse, reported here, will be particularly suitable for breeding with mice expressing antisickling globins: The low adult HbF will not complicate interpretation, it has short survival after birth (an outcome target in itself), and it has very high reticulocyte count and low hematocrit. Comparing the effect of breeding an antisickling globin into NY1KO γL mice with the effect of high adult HbF in NY1KO γM and NY1KO γH mice will allow the efficacy of antisickling globins to be evaluated.
Acknowledgments
We thank Chris Pàszty, Oliver Smithies, Bernard Forget, and Ramesh Kumar for contributing mice with useful transgenes and knockouts and for their thoughtful suggestions. We also thank Raouf Alami and Eric Bouhassira for F-cell measurements and Thomas Campbell of Wallac, a Perkin Elmer Life Science Company, for provision of FITC-labeled γ-antibody.
Supported in part by NIH grants P01-HL-55435, P60-HL-38655, 1M01 RR 12248, P60-HL-28381, HL-37001, and HL63455.
The publication costs of this article were defrayed in part by page charge payment. Therefore, and solely to indicate this fact, this article is hereby marked “advertisement” in accordance with 18 U.S.C. section 1734.
References
Author notes
Mary E. Fabry, Department of Medicine, Ullmann Room 921, Albert Einstein College of Medicine, 1300 Morris Park Ave, Bronx, NY 10461; e-mail: fabry@aecom.yu.edu.

This feature is available to Subscribers Only
Sign In or Create an Account Close Modal